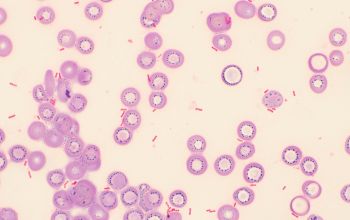
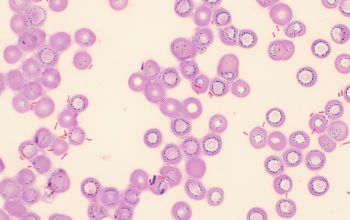
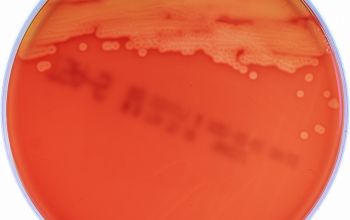
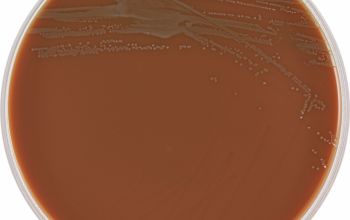
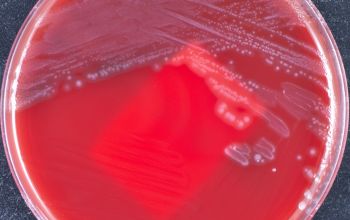

Kingella kingae
-
General information
Taxonomy
Family: Neisseriaceae
K. kingae
K. denitrificans
K. oralis
HACEK
The HACEK organisms are a group of fastidious Gram-negative bacteria that are an unusual cause of infective endocarditis, which is an inflammation of the heart due to bacterial infection.
HACEK is an abbreviation of the initials of the genera of this group of bacteria:
Haemophilus aphrophilus (Aggregatibacter aphrophilus)
Aggregatibacter actinomycetemcomitans (previously Actinobacillus)
Cardiobacterium hominis
Eikenella corrodens
Kingella kingae.
The HACEK organisms are a normal part of the human microbiota, living in the oral-pharyngeal region.
The bacteria were originally grouped because they were thought to be a significant cause of infective endocarditis, but recent research has shown that they are rare and only responsible for 1.4–3.0% of all cases of this disease.
Natural habitats
They colonizes the throat but not the nasopharynx of many children ged 6month to 4 years.
Clinical significans
They show a predilection for bones an joints of previously healthy children under 4 years of age.
Infections in adults occur more commonly in immunocompromised individuals or may present as HACEK endocarditis.
Recovery from body fluids and pus can be difficult because these specimens seem to be inhibitory to the bacteria.
-
Gram stain
Short Gram negative rods,
with square ends which lie together in pairs or clusters
and tend to decolorize unevenly on Gram stain
-
Culture characteristics
-
Facultative anaerobic
5% CO2 improves the growth
BA: 2 types, after 48h colonies are 1-2mm
1) colonies are smooth with a central papilla, small zone of hemolysis
2) colonies showing spreading edges and pitting of the medium, small zone of hemolysis
McConkey: no growth
BBAØ: growth
Viability is limited
-
-
Characteristics
-
References
James Versalovic et al.(2011) Manual of Clinical Microbiology 10th Edition
Karen C. Carrol et al (2019) Manual of Clinical Microbiology, 12th Edition